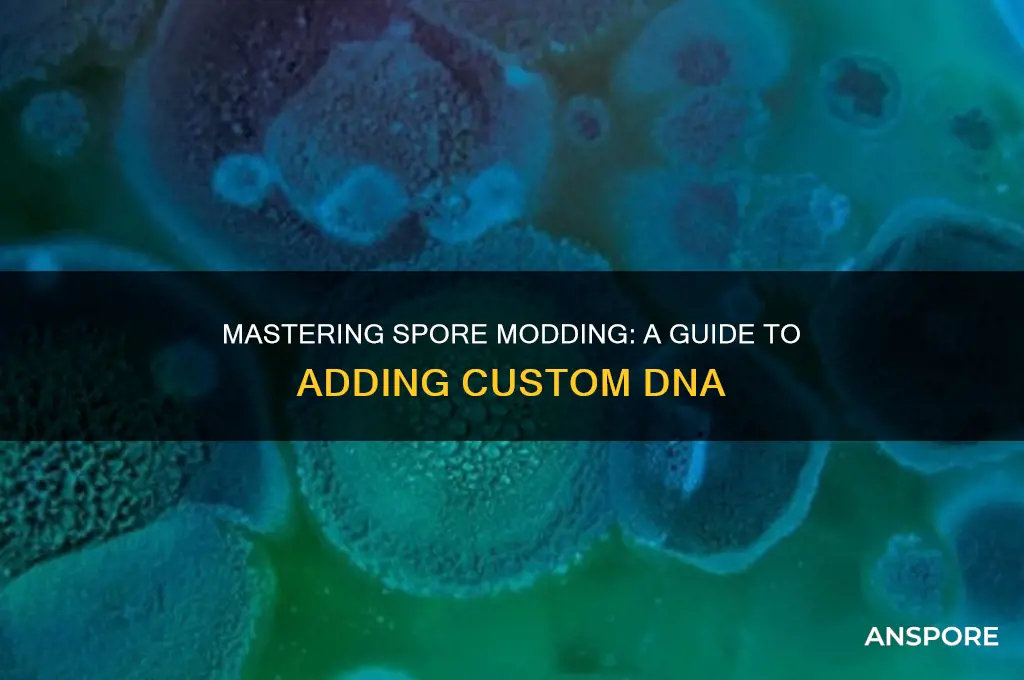
how to add dna in spore

Adding DNA in *Spore* allows players to customize and enhance their creatures by incorporating specific traits and abilities. This feature, available in the Creature Creator, enables users to modify their organisms at a genetic level, influencing attributes such as speed, strength, and social skills. By selecting and combining different DNA strands, players can create unique creatures tailored to their gameplay style or creative vision. Understanding how to effectively add and manipulate DNA not only deepens the game’s strategic elements but also fosters a greater appreciation for the biological concepts that inspire *Spore*’s design. Whether aiming for survival, dominance, or aesthetic appeal, mastering DNA customization is key to unlocking the full potential of your creatures in this evolutionary simulation game.
Explore related products
What You'll Learn
- Extracting DNA: Methods for isolating DNA from source organisms, ensuring purity for successful integration
- Editing DNA: Tools like CRISPR for modifying DNA sequences before insertion into spores
- Transformation Techniques: Methods (e.g., electroporation, heat shock) to introduce DNA into spores
- Selecting Transformants: Using markers (e.g., antibiotics) to identify spores with successfully added DNA
- Verification Methods: PCR, sequencing, or phenotypic assays to confirm DNA integration in spores

Extracting DNA: Methods for isolating DNA from source organisms, ensuring purity for successful integration
DNA extraction is the critical first step in adding genetic material to *Spore*, whether for modding or experimental purposes. The success of this process hinges on isolating high-purity DNA from source organisms, free from contaminants like proteins, RNA, or cell debris. Common methods include the phenol-chloroform extraction, which leverages phase separation to isolate DNA, and the silica-based column purification, often used in commercial kits for its simplicity and efficiency. Each method has trade-offs: phenol-chloroform yields high-purity DNA but requires hazardous chemicals, while silica columns are safer but may sacrifice yield. Choosing the right method depends on the organism’s complexity and the intended application in *Spore*.
For successful integration into *Spore*, the extracted DNA must meet specific criteria. Purity is paramount, as contaminants can disrupt the game’s modding tools or experimental systems. A 260/280 nm absorbance ratio of ~1.8 indicates RNA-free DNA, while a 260/230 nm ratio above 2.0 confirms the absence of proteins and salts. Practical tips include using RNase during extraction to degrade RNA and performing multiple washes during column purification to remove impurities. For *Spore* modding, DNA fragments should be small (under 5 kb) to ensure compatibility with the game’s genetic system, though larger constructs may require advanced tools like CRISPR-Cas9 for integration.
Comparing extraction methods reveals their suitability for different source organisms. For bacteria, a simple boiling lysis method often suffices, releasing DNA with minimal effort. Plant tissues, rich in polysaccharides and polyphenols, require additional steps like CTAB buffer treatment to break down cell walls. Animal cells, with their complex membranes, benefit from enzymatic digestion with proteinase K before phenol-chloroform extraction. Each approach must balance efficiency, cost, and purity, as impure DNA can lead to failed integrations or unpredictable behavior in *Spore*’s simulation environment.
Persuasively, investing time in optimizing DNA extraction pays dividends in *Spore*’s modding or experimental outcomes. A well-isolated DNA sample ensures seamless integration, allowing for the creation of novel creatures or behaviors without glitches. For instance, using a commercial kit like Qiagen’s DNeasy Blood & Tissue Kit guarantees consistency, ideal for beginners. Advanced users might prefer the phenol-chloroform method for its flexibility in handling diverse organisms. Regardless of the method, verifying DNA quality through gel electrophoresis or spectrophotometry is non-negotiable, as it confirms the sample’s readiness for *Spore*’s genetic framework.
In conclusion, extracting DNA for *Spore* requires a tailored approach, balancing the organism’s characteristics with the desired purity and yield. Whether using a simple boiling method or a sophisticated column kit, the goal remains the same: obtaining uncontaminated DNA ready for integration. By mastering these techniques, users can unlock *Spore*’s full potential, crafting genetic modifications that enhance gameplay or scientific exploration. Remember, the purity of your DNA is the foundation of your success—skimp on extraction, and your *Spore* creations may never come to life.
Can Mold Spores Trigger Itching in Small Dogs? Exploring the Link
You may want to see also

Editing DNA: Tools like CRISPR for modifying DNA sequences before insertion into spores
CRISPR-Cas9 has revolutionized the way we approach DNA editing, offering precision and efficiency previously unimaginable. When preparing to add DNA into spores, this tool becomes invaluable for modifying sequences to ensure compatibility, functionality, or desired traits. The process begins with identifying the target sequence in the spore’s genome or the exogenous DNA to be inserted. CRISPR’s guide RNA (gRNA) is designed to match this sequence, directing the Cas9 enzyme to the exact location for a double-stranded break. This break triggers the cell’s natural repair mechanisms, either through non-homologous end joining (NHEJ) or homology-directed repair (HDR), allowing for insertion, deletion, or alteration of DNA segments. For spore engineering, this step is critical to ensure the new DNA integrates seamlessly without disrupting essential spore functions.
To implement CRISPR in spore DNA editing, start by synthesizing the gRNA and Cas9 components tailored to your target organism. For example, in *Bacillus subtilis* spores, a common model for spore research, the gRNA sequence should be 20 nucleotides long, complementary to the target site, and followed by the PAM sequence (NGG). The Cas9 protein can be delivered as a plasmid or directly as a ribonucleoprotein (RNP) complex. Dosage is key: a concentration of 50–100 nM of Cas9 and 100–200 nM of gRNA is typically effective for efficient editing in bacterial systems. Ensure the donor DNA template for HDR is present in sufficient quantity (100–500 ng) to promote precise integration of the desired sequence. Electroporation or protoplast transformation methods can be used to deliver these components into the spore-forming cells, with electroporation often yielding higher efficiency.
One of the challenges in using CRISPR for spore DNA editing is ensuring the survival and functionality of the spore post-editing. Spores are highly resilient structures, but the editing process can introduce stress that affects germination or viability. To mitigate this, optimize the editing protocol by minimizing off-target effects through careful gRNA design and using high-fidelity Cas9 variants. Additionally, screen edited spores for the desired traits using PCR or sequencing to confirm successful integration. For long-term storage, maintain edited spores at -80°C in a solution containing 20% glycerol to preserve viability. Practical tips include using a gentle germination protocol (e.g., nutrient broth at 37°C) to assess spore functionality after editing.
Comparing CRISPR to traditional DNA editing methods like restriction enzymes or homologous recombination highlights its advantages in spore engineering. Traditional methods often require laborious cloning steps and lack the precision to target specific sequences without affecting others. CRISPR, on the other hand, allows for multiplex editing, enabling simultaneous modification of multiple genes or insertion of complex pathways into spores. For instance, engineering spores to express antimicrobial peptides or enzymes for bioremediation becomes more feasible with CRISPR’s efficiency. However, CRISPR is not without limitations; its reliance on the PAM sequence restricts target sites, and off-target effects remain a concern. Combining CRISPR with other tools, such as base editors or prime editing, can address these limitations, offering a more versatile toolkit for spore DNA modification.
In conclusion, CRISPR-based DNA editing is a powerful approach for modifying sequences before insertion into spores, enabling precise and efficient genetic engineering. By following a structured protocol—from gRNA design to delivery and screening—researchers can harness this technology to create spores with tailored functionalities. While challenges like off-target effects and spore viability persist, ongoing advancements in CRISPR technology continue to expand its potential in spore engineering. Whether for biotechnology, agriculture, or medicine, mastering CRISPR for spore DNA editing opens new frontiers in leveraging these resilient organisms for practical applications.
Exploring Spore's Multiplayer: Does the Game Offer Online Play?
You may want to see also

Transformation Techniques: Methods (e.g., electroporation, heat shock) to introduce DNA into spores
Introducing foreign DNA into spores is a delicate dance, requiring methods that breach the spore's robust protective barrier without compromising its viability. Two prominent techniques, electroporation and heat shock, offer distinct advantages and challenges in this endeavor. Electroporation employs high-voltage electric pulses to create transient pores in the spore's membrane, allowing DNA entry. This method boasts high efficiency, particularly for larger DNA constructs, but demands precise control over pulse parameters to avoid spore damage. Optimal conditions often involve voltages ranging from 10-25 kV/cm, pulse lengths of 5-10 ms, and a single pulse application.
Heat shock, a simpler and more cost-effective approach, leverages temperature differentials to induce DNA uptake. Spores are typically incubated with DNA at 37°C, followed by a rapid heat shock at 42°C for 30-90 seconds. While less efficient than electroporation, heat shock is gentler on spores and suitable for smaller DNA molecules.
The choice between these methods hinges on the specific experimental goals and spore characteristics. Electroporation excels in delivering large plasmids or complex genetic circuits, making it ideal for sophisticated genetic engineering applications. However, its technical complexity and potential for spore damage necessitate careful optimization. Heat shock, with its simplicity and lower risk of spore injury, is a preferred choice for routine transformations involving smaller DNA fragments.
Beyond these established techniques, emerging methods like chemical transformation and biolistics offer alternative avenues for DNA delivery. Chemical transformation utilizes calcium chloride or other chemicals to increase spore membrane permeability, while biolistics employs particle bombardment to physically propel DNA into spores. These methods, though less widely used, showcase the ongoing innovation in spore transformation techniques, expanding the toolkit for researchers seeking to manipulate spore genetics.
Practical considerations play a crucial role in successful spore transformation. DNA quality and concentration, spore age and viability, and buffer composition significantly impact transformation efficiency. Freshly prepared, high-quality DNA and young, actively germinating spores generally yield better results. Additionally, optimizing buffer conditions, such as pH and ionic strength, can enhance DNA uptake and spore survival.
In conclusion, the choice of transformation technique depends on a delicate balance between efficiency, simplicity, and spore viability. Electroporation and heat shock remain the cornerstone methods, each with its strengths and limitations. As research progresses, novel approaches like chemical transformation and biolistics promise to further expand the possibilities for genetic manipulation of spores, opening new avenues for applications in biotechnology, agriculture, and medicine.
Spore Strip Testing: Optimal Waiting Time for Accurate Results
You may want to see also
Explore related products

Selecting Transformants: Using markers (e.g., antibiotics) to identify spores with successfully added DNA
Antibiotic resistance markers are a cornerstone of selecting transformants in spore engineering. By incorporating a gene conferring resistance to a specific antibiotic (e.g., kanamycin, ampicillin) into your DNA construct, you create a built-in selection mechanism. Spores that successfully uptake and express the foreign DNA will survive antibiotic treatment, while untransformed spores perish. This method is both elegant and efficient, allowing for rapid identification of desired transformants.
Common antibiotics used include kanamycin (50-100 µg/mL) and ampicillin (50-100 µg/mL), with concentrations adjusted based on the spore species and growth conditions.
The process begins with careful planning. Your DNA construct must include the antibiotic resistance gene alongside your gene of interest. This requires precise molecular cloning techniques, ensuring the resistance gene is under the control of a suitable promoter for expression in the spore. Following transformation, spores are plated on selective media containing the corresponding antibiotic. Only spores harboring the resistance gene will grow, forming visible colonies.
This visual confirmation provides a clear indication of successful DNA integration.
While antibiotic selection is powerful, it's not without limitations. False positives can occur due to spontaneous mutations conferring resistance. To mitigate this, consider using a combination of markers or employing more stringent selection conditions. Additionally, some spore species may exhibit inherent resistance to certain antibiotics, necessitating alternative selection strategies.
Beyond antibiotics, other markers can be employed. Fluorescent proteins like GFP allow for visual identification of transformants under a fluorescence microscope. This method is particularly useful for studying gene expression patterns within individual spores. However, it requires specialized equipment and may not be as high-throughput as antibiotic selection.
Ultimately, the choice of marker depends on the specific research goals and the characteristics of the spore species being studied.
Can Spores Survive Freezing? Unveiling Their Resilience in Cold Conditions
You may want to see also

Verification Methods: PCR, sequencing, or phenotypic assays to confirm DNA integration in spores
Once DNA is introduced into spores, confirming its successful integration is critical. Verification ensures the genetic modification took hold, laying the groundwork for further experimentation or application. Three primary methods dominate this confirmation process: PCR, sequencing, and phenotypic assays, each offering distinct advantages and considerations.
PCR, or polymerase chain reaction, acts as a molecular detective, amplifying specific DNA sequences for detection. Design primers targeting the inserted DNA sequence and flanking regions within the spore's genome. If amplification occurs, it strongly suggests successful integration. This method is rapid, cost-effective, and highly sensitive, detecting even low levels of integrated DNA. However, PCR merely confirms the presence of the DNA fragment, not its functionality or precise location.
Sequencing, the gold standard for verification, provides the most comprehensive confirmation. By deciphering the exact DNA sequence, researchers can pinpoint the insertion site, verify the integrity of the inserted DNA, and identify any unintended mutations. While Sanger sequencing offers a targeted approach, next-generation sequencing (NGS) allows for whole-genome analysis, revealing the broader context of the integration event. Sequencing is more expensive and time-consuming than PCR but delivers unparalleled detail, crucial for understanding the genetic modification's implications.
Phenotypic assays take a different approach, focusing on the observable characteristics resulting from the DNA integration. This method relies on the inserted DNA encoding a gene that confers a measurable trait, such as antibiotic resistance, fluorescence, or altered spore morphology. If the spores exhibit the expected phenotype, it strongly suggests successful integration and functional expression of the introduced gene. Phenotypic assays are straightforward and visually intuitive but require the inserted DNA to encode a readily detectable trait.
Choosing the most suitable verification method depends on the specific research goals and resources available. PCR offers a quick initial confirmation, sequencing provides detailed genetic insight, and phenotypic assays directly demonstrate gene function. Often, a combination of these methods is employed for robust verification, ensuring the DNA is not only present but also functionally integrated into the spore's genome.
Windex and Mold: Can It Effectively Kill Mold Spores?
You may want to see also
Frequently asked questions
In Spore, DNA is not directly added but is represented through the evolution and customization of your creature. You can modify your creature's DNA-like traits by using the Creature Editor, where you can add or adjust body parts, abilities, and behaviors.
Spore does not support importing external DNA files. All customization must be done within the game's built-in editors, such as the Creature Editor or the Adventure Creator.
More DNA options (like body parts and abilities) are unlocked as you progress through the game's stages, complete missions, or achieve specific milestones. Exploring and advancing in the game will naturally expand your customization choices.
Yes, you can edit your creature's DNA-like traits at any stage of the game by returning to the Creature Editor. However, changes made later may not affect certain pre-existing game elements or saved progress.























